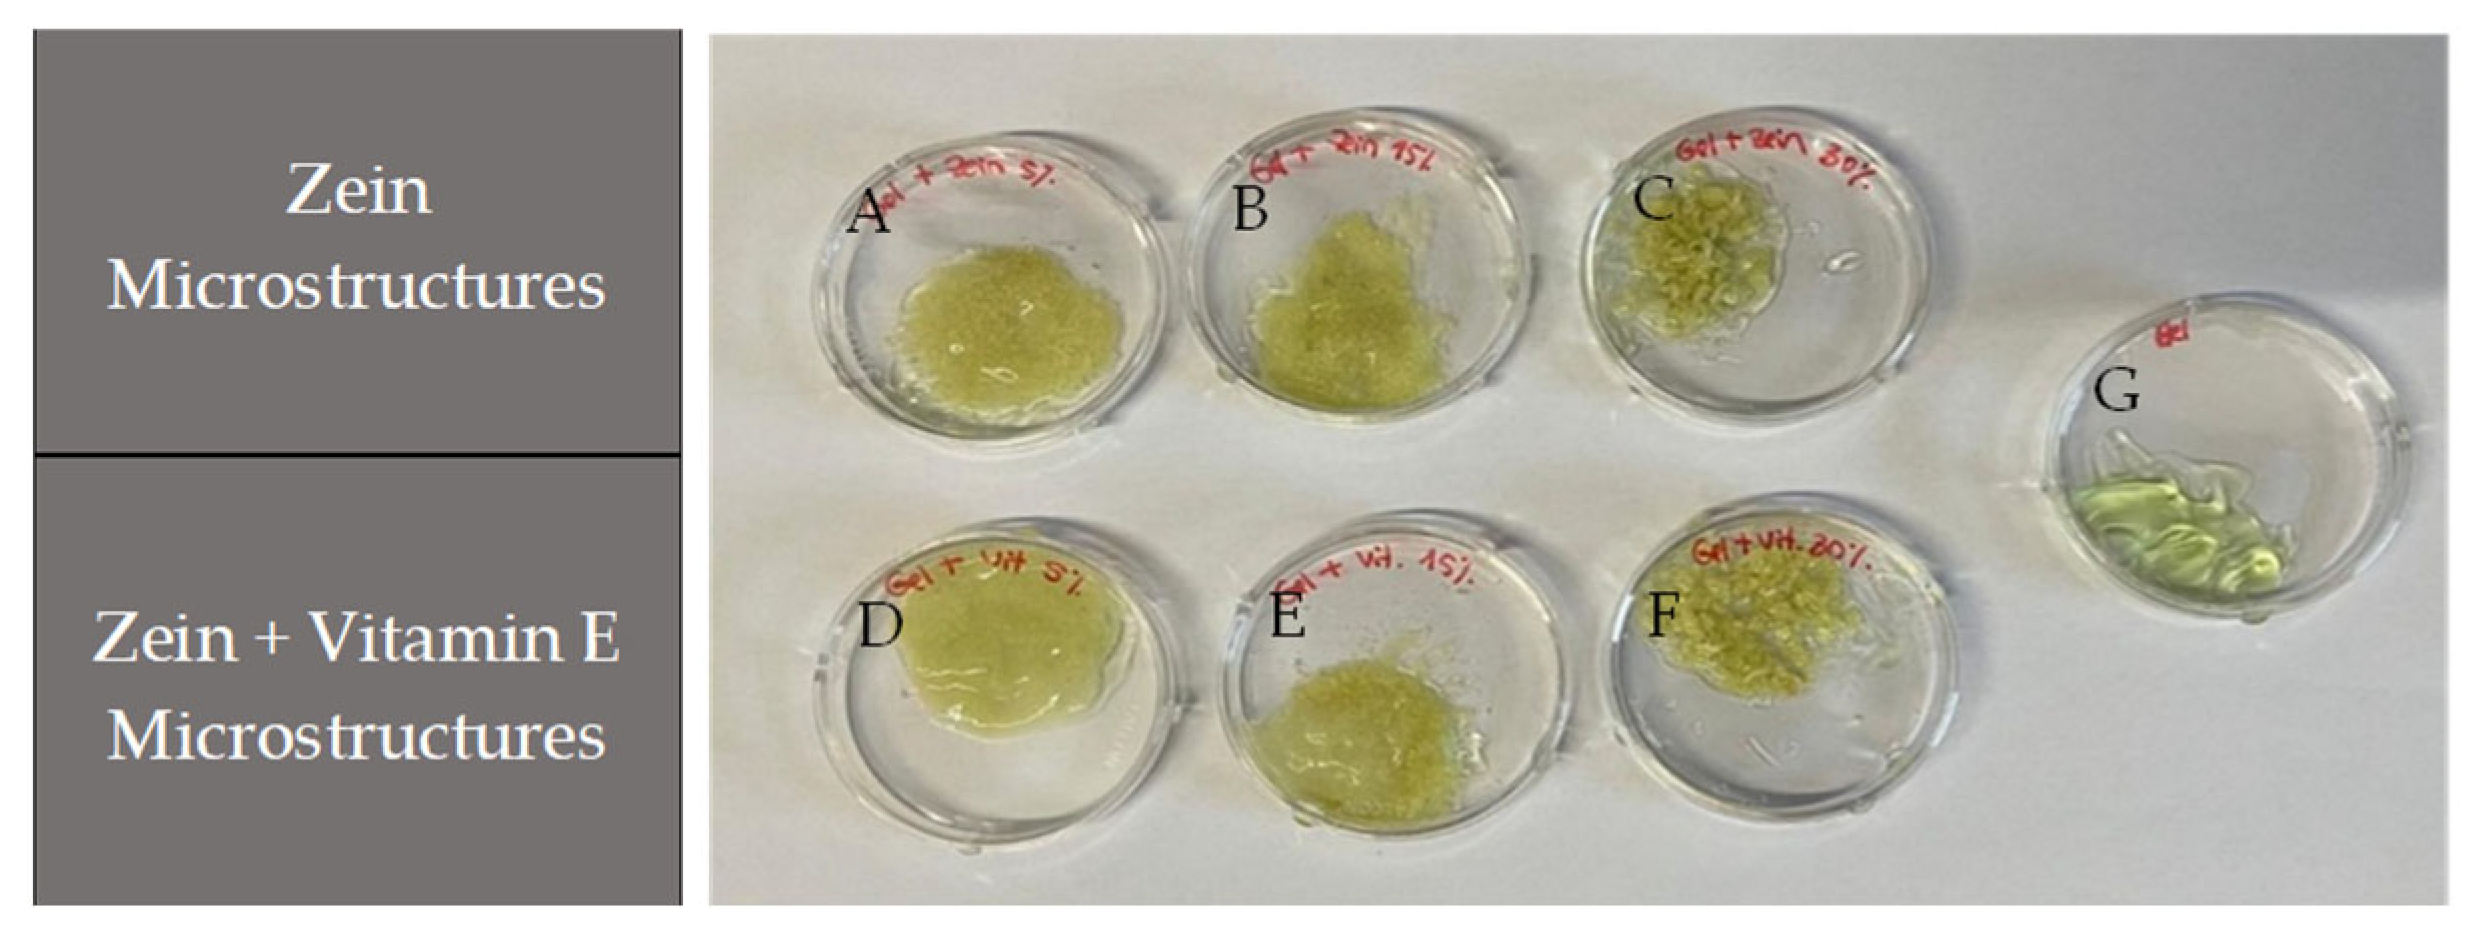
Molecules 30 02306 g005

Vitamin E Microencapsulation via Electrohydrodynamic Techniques for Potential Use in Skin Care and Dermatological Applications
Abstract
1. Introduction
2. Results and Discussion
2.1. Microstructure Characterization
2.1.1. Conductivity
2.1.2. pH
2.1.3. Optical Microscope
2.1.4. Scanning Electron Microscopy (SEM)
2.1.5. Release Studies
2.2. Cosmetic Application
2.2.1. Hydrogel with Microstructures of Vitamin E
2.2.2. Coconut Oil with Microstructures of Vitamin E
3. Materials and Methods
3.1. Reagents and Solutions
3.2. Sample Preparation
3.3. Conductivity and pH of Zein Solutions
3.4. Production of Microstructures by EHD Techniques
3.5. Microstructure Characterization
3.6. Release Assays
3.7. Calibration Curve
3.8. Application of Microstructures with a Cosmetic Compound
3.9. Statistical Analysis
4. Conclusions
Author Contributions
Funding
Institutional Review Board Statement
Informed Consent Statement
Data Availability Statement
Acknowledgments
Conflicts of Interest
Abbreviations
| α-TOC | α-tocopherol |
| α-TAc | α-tocopherol acetate |
| β-CD | β-cyclodextrin |
| EHD | Electrohydrodynamic techniques |
| FDA | Food and Drug Administration |
| MAAP | Magnesium l-ascorbic acid 2-phosphate |
| PAN | polyacrylonitrile |
| PCL | poly(ε-caprolactone) |
| SPI | Soybean protein isolate |
| WPI | Whey protein isolate |
References
- Ribeiro, A.M.; Estevinho, B.N.; Rocha, F. Improvement of Vitamin E Microencapsulation and Release Using Different Biopolymers as Encapsulating Agents. Food Bioprod. Process. 2021, 130, 23–33. [Google Scholar] [CrossRef]
- Ribeiro, A.M.; Gonçalves, A.; Rocha, F.; Estevinho, B.N. Statistical Simplex Centroid Experimental Design for Evaluation of Pectin, Modified Chitosan and Modified Starch as Encapsulating Agents on the Development of Vitamin E-Loaded Microparticles by Spray-Drying. Int. J. Biol. Macromol. 2024, 269, 131792. [Google Scholar] [CrossRef]
- Coelho, S.C.; Estevinho, B.N.; Rocha, F. Encapsulation in Food Industry with Emerging Electrohydrodynamic Techniques: Electrospinning and Electrospraying—A Review. Food Chem. 2021, 339, 127850. [Google Scholar] [CrossRef] [PubMed]
- Coelho, S.C.; Estevinho, B.N. A Brief Review on the Electrohydrodynamic Techniques Used to Build Antioxidant Delivery Systems from Natural Sources. Molecules 2023, 28, 3592. [Google Scholar] [CrossRef]
- Akhtar, N.; Akhtar, N.; Menaa, F.; Alharbi, W.; Alaryani, F.S.S.; Alqahtani, A.M.; Ahmad, F. Fabrication of Ethosomes Containing Tocopherol Acetate to Enhance Transdermal Permeation: In Vitro and Ex Vivo Characterizations. Gels 2022, 8, 335. [Google Scholar] [CrossRef]
- McVean, M.; Liebler, D.C. Prevention of DNA Photodamage by Vitamin E Compounds and Sunscreens: Roles of Ultraviolet Absorbance and Cellular Uptake. Mol. Carcinog. 1999, 24, 169–176. [Google Scholar] [CrossRef]
- Wu, X.M.; Branford-White, C.J.; Yu, D.G.; Chatterton, N.P.; Zhu, L.M. Preparation of Core-Shell PAN Nanofibers Encapsulated α-Tocopherol Acetate and Ascorbic Acid 2-Phosphate for Photoprotection. Colloids Surf. B Biointerfaces 2011, 82, 247–252. [Google Scholar] [CrossRef] [PubMed]
- Keen, M.; Hassan, I. Vitamin E in Dermatology. Indian Dermatol. Online J. 2016, 7, 311. [Google Scholar] [CrossRef]
- Sosa, A.M.; Igartúa, D.E.; Martínez, L.M.; Alonso, S.d.V.; Prieto, M.J.; Martinez, C.S. Multifunctional Emulsion for Potential Wound-Healing Applications: A Development for Co-Administration of Essential Vitamins, Silver Nanoparticles, and Potent Active Ingredients. J. Drug Deliv. Sci. Technol. 2024, 101, 106128. [Google Scholar] [CrossRef]
- Praça, F.G.; Viegas, J.S.R.; Peh, H.Y.; Garbin, T.N.; Medina, W.S.G.; Bentley, M.V.L.B. Microemulsion Co-Delivering Vitamin A and Vitamin E as a New Platform for Topical Treatment of Acute Skin Inflammation. Mater. Sci. Eng. C 2020, 110, 110639. [Google Scholar] [CrossRef]
- Ravisankar, P.; Reddy, A.A.; Nagalakshmi, B.; Koushik, O.S.; Kumar, B.V.; Anvith, P.S. The Comprehensive Review on Fat Soluble Vitamins. IOSR J. Pharm. 2015, 5, 12–28. [Google Scholar]
- Ribeiro, A.M.; Estevinho, B.N.; Rocha, F. The Progress and Application of Vitamin E Encapsulation—A Review. Food Hydrocoll. 2021, 121, 106998. [Google Scholar] [CrossRef]
- Gonçalves, A.; Estevinho, B.N.; Rocha, F. Design and Characterization of Controlled-Release Vitamin A Microparticles Prepared by a Spray-Drying Process. Powder Technol. 2017, 305. [Google Scholar] [CrossRef]
- Wilson, N.; Shah, N.P. Microencapsulation of Vitamins. Int. Food Res. J. 2007, 14, 1–14. [Google Scholar]
- Gonçalves, A.; Estevinho, B.N.; Rocha, F. Microencapsulation of Vitamin A: A Review. Trends Food Sci. Technol. 2016, 51, 76–87. [Google Scholar] [CrossRef]
- Peanparkdee, M.; Iwamoto, S.; Yamauchi, R. Microencapsulation: A Review of Applications in the Food and Pharmaceutical Industries. Rev. Agric. Sci. 2016, 4, 56–65. [Google Scholar] [CrossRef]
- Loreal Paris. A Closer Look at Microencapsulation in Cosmetics. Available online: https://www.lorealparis.co.in/beauty-magazine/skin-care-blogs/a-closer-look-at-microencapsulation-in-cosmetics (accessed on 20 January 2025).
- Jyothi, N.V.N.; Prasanna, P.M.; Sakarkar, S.N.; Prabha, K.S.; Ramaiah, P.S.; Srawan, G.Y. Microencapsulation Techniques, Factors Influencing Encapsulation Efficiency. J. Microencapsul. 2010, 27, 187–197. [Google Scholar] [CrossRef]
- Srivastava, S.; Pandey, V.K.; Dar, A.H.; Shams, R.; Dash, K.K.; Rafiq, S.M.; Zahoor, I.; Kumar, S. Effect of Microencapsulation Techniques on the Different Properties of Bioactives, Vitamins and Minerals. Food Sci. Biotechnol. 2024, 33, 3181–3198. [Google Scholar] [CrossRef]
- Suave, J.; Dall’agnol, E.C.; Pezzin, A.P.T.; Silva, D.A.K.; Meier, M.M.; Soldi, V. Microencapsulação: Inovação Em Diferentes Áreas. Rev. Saúde e Ambient./Heal. Environ. J. 2006, 7, 12–20. [Google Scholar]
- Huang, K.; Yuan, Y.; Baojun, X. A Critical Review on the Microencapsulation of Bioactive Compounds and Their Application. Food Rev. Int. 2023, 39, 2594–2634. [Google Scholar] [CrossRef]
- Jacobsen, C.; García-Moreno, P.J.; Mendes, A.C.; Mateiu, R.V.; Chronakis, I.S. Use of Electrohydrodynamic Processing for Encapsulation of Sensitive Bioactive Compounds and Applications in Food. Annu. Rev. Food Sci. Technol. 2018, 9, 525–549. [Google Scholar] [CrossRef] [PubMed]
- Silva, P.M.; Torres-Giner, S.; Vicente, A.A.; Cerqueira, M.A. Electrohydrodynamic Processing for the Production of Zein-Based Microstructures and Nanostructures. Curr. Opin. Colloid Interface Sci. 2021, 56, 101504. [Google Scholar] [CrossRef]
- Bhushani, J.A.; Anandharamakrishnan, C. Electrospinning and Electrospraying Techniques: Potential Food Based Applications. Trends Food Sci. Technol. 2014, 38, 21–33. [Google Scholar] [CrossRef]
- Fabra, M.J.; López-Rubio, A.; Lagaron, J.M. Use of the Electrohydrodynamic Process to Develop Active/Bioactive Bilayer Films for Food Packaging Applications. Food Hydrocoll. 2016, 55, 11–18. [Google Scholar] [CrossRef]
- Singchuwong, T.; Nankuntod, K.; Stapornpiriyadaj, K.; Leepasert, T.; Karpkird, T. Fabrication and Characterization Electrospun Nanofibers of Vitamin E-Loaded Poly(Vinyl Alcohol) and Hydroxy-Beta-Cyclodextrin Crosslinked by Citric Acid. Int. J. Polym. Mater. Polym. Biomater. 2024, 74, 93–102. [Google Scholar] [CrossRef]
- Drosou, C.G.; Krokida, M.K.; Biliaderis, C.G. Encapsulation of Bioactive Compounds through Electrospinning/Electrospraying and Spray Drying: A Comparative Assessment of Food-Related Applications. Dry. Technol. 2017, 35, 139–162. [Google Scholar] [CrossRef]
- Zare, M.; Dziemidowicz, K.; Williams, G.R.; Ramakrishna, S. Encapsulation of Pharmaceutical and Nutraceutical Active Ingredients Using Electrospinning Processes. Nanomaterials 2021, 11, 1968. [Google Scholar] [CrossRef]
- Aytac, Z.; Uyar, T. Antioxidant Activity and Photostability of α-Tocopherol/β-Cyclodextrin Inclusion Complex Encapsulated Electrospun Polycaprolactone Nanofibers. Eur. Polym. J. 2016, 79, 140–149. [Google Scholar] [CrossRef]
- Peh, H.Y.; Tan, W.S.D.; Liao, W.; Wong, W.S.F. Vitamin E Therapy beyond Cancer: Tocopherol versus Tocotrienol. Pharmacol. Ther. 2016, 162, 152–169. [Google Scholar] [CrossRef]
- Munteanu, B.S.; Vasile, C. Encapsulation of Natural Bioactive Compounds by Electrospinning—Applications in Food Storage and Safety. Polymers 2021, 13, 3771. [Google Scholar] [CrossRef]
- Li, H.; Wang, M.; Williams, G.R.; Wu, J.; Sun, X.; Lv, Y.; Zhu, L.M. Electrospun Gelatin Nanofibers Loaded with Vitamins A and e as Antibacterial Wound Dressing Materials. RSC Adv. 2016, 6, 50267–50277. [Google Scholar] [CrossRef]
- Smith, D.; Reneker, D.; Kataphinan, W.; Dabney, S. Electrospun Skin Masks and Uses Thereof. WO2001026610A1, 19 April 2001. [Google Scholar]
- Gwangju, C.K. Cosmetic Sheet Formed from Nanofiber with Controlled Dissolution Velocity and Method of Manufacturing the Same. US20150272855A1, 23 October 2013. [Google Scholar]
- Kalantary, S.; Golbabaei, F.; Latifi, M.; Shokrgozar, M.A.; Yaseri, M. Feasibility of Using Vitamin E-Loaded Poly(e-Caprolactone)/Gelatin Nanofibrous Mat to Prevent Oxidative Stress in Skin. J. Nanosci. Nanotechnol. 2019, 20, 3554–3562. [Google Scholar] [CrossRef]
- Sheng, X.; Fan, L.; He, C.; Zhang, K.; Mo, X.; Wang, H. Vitamin E-Loaded Silk Fibroin Nanofibrous Mats Fabricated by Green Process for Skin Care Application. Int. J. Biol. Macromol. 2013, 56, 49–56. [Google Scholar] [CrossRef]
- Taepaiboon, P.; Rungsardthong, U.; Supaphol, P. Vitamin-Loaded Electrospun Cellulose Acetate Nanofiber Mats as Transdermal and Dermal Therapeutic Agents of Vitamin A Acid and Vitamin E. Eur. J. Pharm. Biopharm. 2007, 67, 387–397. [Google Scholar] [CrossRef] [PubMed]
- Couto, A.F.; Favretto, M.; Paquis, R.; Estevinho, B.N. Co-Encapsulation of Epigallocatechin-3-Gallate and Vitamin B12 in Zein Microstructures by Electrospinning/ Electrospraying Technique. Molecules 2023, 28, 2544. [Google Scholar] [CrossRef]
- Coelho, S.C.; Rocha, F.; Estevinho, B.N. Electrospinning of Microstructures Incorporated with Vitamin B9 for Food Application: Characteristics and Bioactivities. Polymers 2022, 14, 4337. [Google Scholar] [CrossRef]
- Yang, J.; Xie, J.; Paximada, E. Electrosprayed Zein and Quercetin Particles: Formation and Properties. Food Bioprocess Technol. 2024, 18, 2840–2853. [Google Scholar] [CrossRef]
- Ali, S.; Khatri, Z.; Oh, K.W.; Kim, I.S.; Kim, S.H. Zein/Cellulose Acetate Hybrid Nanofibers: Electrospinning and Characterization. Macromol. Res. 2014, 22, 971–977. [Google Scholar] [CrossRef]
- Huang, W.; Zou, T.; Li, S.; Jing, J.; Xia, X.; Liu, X. Drug-Loaded Zein Nanofibers Prepared Using a Modified Coaxial Electrospinning Process. AAPS PharmSciTech 2013, 14, 675–681. [Google Scholar] [CrossRef]
- Ansarifar, E.; Moradinezhad, F. Encapsulation of Thyme Essential Oil Using Electrospun Zein Fiber for Strawberry Preservation. Chem. Biol. Technol. Agric. 2022, 9, 1–11. [Google Scholar] [CrossRef]
- Gómez-Mascaraque, L.G.; Perez-Masiá, R.; González-Barrio, R.; Periago, M.J.; López-Rubio, A. Potential of Microencapsulation through Emulsion-Electrospraying to Improve the Bioaccesibility of β-Carotene. Food Hydrocoll. 2017, 73, 1–12. [Google Scholar] [CrossRef]
- Rezazadeh, A.; Kia, E.M.; Hamishehkar, H.; Jahani, B.K.G.; Ghasempour, Z. Capsaicin-Incorporated Zein Electrospun Nanofibers: Characterization and Release Behavior. Food Biosci. 2022, 49, 101843. [Google Scholar] [CrossRef]
- Coelho, S.C.; Laget, S.; Benaut, P.; Rocha, F.; Estevinho, B.N. A New Approach to the Production of Zein Microstructures with Vitamin B12, by Electrospinning and Spray Drying Techniques. Powder Technol. 2021, 392, 47–57. [Google Scholar] [CrossRef]
- Ahmadi Bonakdar, M.; Rodrigue, D. Electrospinning: Processes, Structures, and Materials. Macromol 2024, 4, 58–103. [Google Scholar] [CrossRef]
- Couto, A.F.; Estevinho, B.N. Valorization of Agricultural By-Products (Fragaria vesca) through the Production of Value-Added Micro/Nanostructures Using Electrohydrodynamic Techniques. Foods 2024, 13, 1162. [Google Scholar] [CrossRef]
- Tarun, J.; Susan, J.; Suria, J.; Susan, V.J.; Criton, S. Evaluation of PH of Bathing Soaps and Shampoos for Skin and Hair Care. Indian J. Dermatol. 2014, 59, 442–444. [Google Scholar] [CrossRef]
- Hosseini, F.; Miri, M.A.; Najafi, M.; Soleimanifard, S.; Aran, M. Encapsulation of Rosemary Essential Oil in Zein by Electrospinning Technique. J. Food Sci. 2021, 86, 4070–4086. [Google Scholar] [CrossRef]
- Nicolov, M.; Cocora, M.; Buda, V.; Danciu, C.; Duse, A.O.; Watz, C.; Borcan, F. Hydrosoluble and Liposoluble Vitamins: New Perspectives through ADMET Analysis. Medicina 2021, 57, 1204. [Google Scholar] [CrossRef] [PubMed]
- da Silva Neto, A.S.; Silva, L.M.S.; Neto, B.M. Utilização Do Óleo de Coco Na Produção de Cosméticos: Uma Revisão Bibliográfica. Res. Soc. Dev. 2020, 9, e75491110397. [Google Scholar] [CrossRef]
- Burnett, C.L.; Bergfeld, W.F.; Belsito, D.V.; Klaassen, C.D.; Marks, J.G.; Shank, R.C.; Slaga, T.J.; Snyder, P.W.; Andersen, F.A. Final Report on the Safety Assessment of Cocos Nucifera (Coconut) Oil and Related Ingredients. Int. J. Toxicol. 2011, 30, 5S–16S. [Google Scholar] [CrossRef]
- Tadele, D.T.; Islam, M.S.; Mekonnen, T.H. Zein-Based Nanoparticles and Nanofibers: Co-Encapsulation, Characterization, and Application in Food and Biomedicine. Trends Food Sci. Technol. 2025, 155, 104809. [Google Scholar] [CrossRef]
- Tadele, D.T.; Mekonnen, T.H. Co-Encapsulation of Quercetin and α-Tocopherol Bioactives in Zein Nanoparticles: Synergistic Interactions, Stability, and Controlled Release. ACS Appl. Polym. Mater. 2024, 6, 3767–3777. [Google Scholar] [CrossRef]
- Henning, S.; Adhikari, R. Scanning Electron Microscopy, ESEM, and X-Ray Microanalysis. In Microscopy Methods in Nanomaterials Characterization; Elsevier: Amsterdam, The Netherlands, 2017; pp. 1–30. [Google Scholar] [CrossRef]
- Surjushe, A.; Vasani, R.; Saple, D.G. Aloe Vera: A Short Review. Indian J. Dermatol. 2008, 53, 163–169. [Google Scholar] [CrossRef] [PubMed]

| Formulation | Zein (% (w/v)) | Average (µm) |
|---|---|---|
| With 1% (w/w) Vitamin E | 1 | 0.72 ± 0.19 |
| 5 | 0.38 ± 0.21 | |
| 15 | 0.64 ± 0.29 | |
| 30 | 0.49 ± 0.17 * | |
| Without Vitamin E | 1 | 0.67 ± 0.35 |
| 5 | 0.42 ± 0.13 | |
| 15 | 0.90 ± 0.69 | |
| 30 | 0.74 ± 0.27 * |
| Compound | Solvent | Equation | R2 | LOD (mg/mL) | LOQ (mg/mL) |
|---|---|---|---|---|---|
| Vitamin E | Ethanol 70% | 5.72x + 0.02 | 0.993 | 0.009 | 0.030 |
Disclaimer/Publisher’s Note: The statements, opinions and data contained in all publications are solely those of the individual author(s) and contributor(s) and not of MDPI and/or the editor(s). MDPI and/or the editor(s) disclaim responsibility for any injury to people or property resulting from any ideas, methods, instructions or products referred to in the content. |
© 2025 by the authors. Licensee MDPI, Basel, Switzerland. This article is an open access article distributed under the terms and conditions of the Creative Commons Attribution (CC BY) license (https://creativecommons.org/licenses/by/4.0/).
Share and Cite
Dias, D.; Estevinho, B.N. Vitamin E Microencapsulation via Electrohydrodynamic Techniques for Potential Use in Skin Care and Dermatological Applications. Molecules 2025, 30, 2306. https://doi.org/10.3390/molecules30112306
Dias D, Estevinho BN. Vitamin E Microencapsulation via Electrohydrodynamic Techniques for Potential Use in Skin Care and Dermatological Applications. Molecules. 2025; 30(11):2306. https://doi.org/10.3390/molecules30112306
Chicago/Turabian StyleDias, Daniela, and Berta Nogueiro Estevinho. 2025. "Vitamin E Microencapsulation via Electrohydrodynamic Techniques for Potential Use in Skin Care and Dermatological Applications" Molecules 30, no. 11: 2306. https://doi.org/10.3390/molecules30112306
APA StyleDias, D., & Estevinho, B. N. (2025). Vitamin E Microencapsulation via Electrohydrodynamic Techniques for Potential Use in Skin Care and Dermatological Applications. Molecules, 30(11), 2306. https://doi.org/10.3390/molecules30112306
